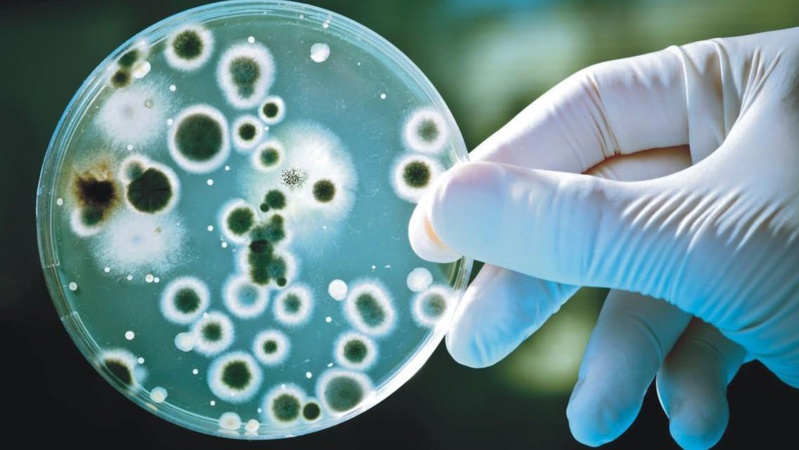
На Волині зареєстровано 12 випадків вірусного гепатиту А

Неділя, 14 червня 2026


Сьогодні, 9 вересня, близько 18-ї години на одній із транспортних розв’язок Луцька сталась ДТП — зіткнулись два легковики

29 серпня в Україні вшановують пам’ять загиблих захисників

Під час брифінгу заступниця генерального директора з дослідження біологічних факторів Волинського обласного ЦКПХ Ірина Єнжиєвська детально розповіла про кишкові інфекції, на які хворіють волиняни.
Серед них – ротавірусний ентерит та вірусний гепатит А.
Про це повідомляє Волинська обласна державна адміністрація.
Хвороби реєструють протягом усього року, проте саме в осінньо-зимовий період збільшується ризик виникнення спалахів інфекції в дитячих організованих колективах.
Так, за останні два роки в області щорічно реєструють понад 300 випадків ротавірусного ентериту, з них 94 % - серед дітей до 17 років.
Натомість з грудня 2023 року в області фіксують підвищення рівня захворюваності на вірусний гепатит А. Зокрема, лише за два тижні цього року вже зареєстровано 12 випадків хвороби, із них 5 – у дітей.
«На сьогодні маємо випадки захворюваності на території Ковельської, Турійської, Маневицької ТГ. Спалахів на даний час не зареєстровано», – зазначила Ірина Єнжиєвська.
Як наголосила посадовиця, інфікуванню кишковими хворобами можна легко запобігти, якщо дотримуватися правил гігієни рук. Найбільш ефективний спосіб захисту – це миття рук з милом і теплою водою щонайменше протягом 20 секунд.
Також для профілактики інфікування як ротавірусного ентериту, так і вірусного гепатиту А існує безпечна та ефективна вакцина. Вона не включена до Національного календаря щеплень, але є рекомендованою.
Головне фото Волинська ОДА.
©2026 uaGit

Коментарі